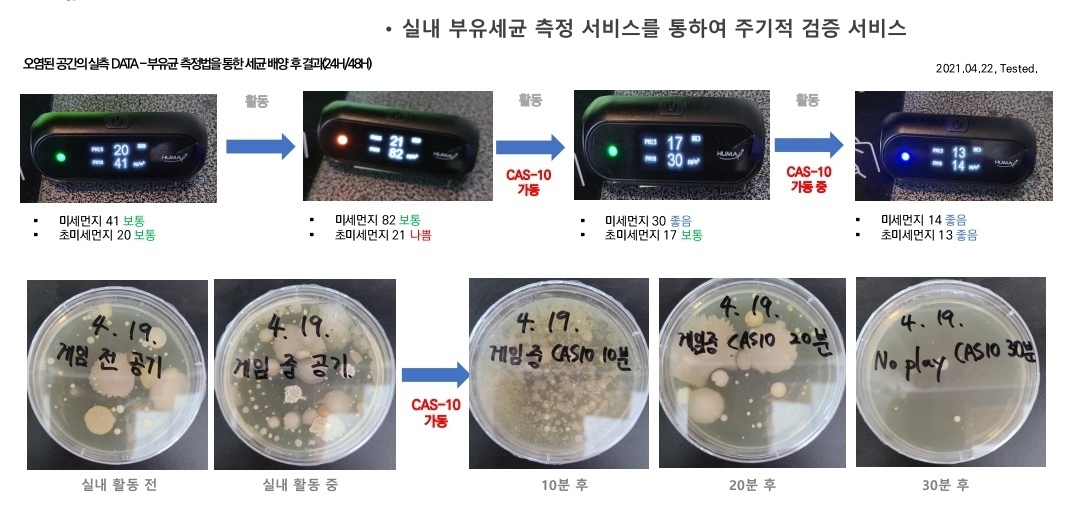

返回

座艙空淨方案——Plasma Ionizer Module
¥1,999.00
Brand New Tech + OION CM600
| 主动净化座艙,免维护更强大
🔹 双极自清洁等离子技术——释放正负离子,高效去除异味、霉菌、细菌、病毒及污染物
🔹 性能跃升——同体积下,功率更强、离子量更高,较 CM300 净化性能大幅提升
🔹 免维护设计——自研自清洁模块,无需清洁配件,适用于风道、空调内部等隐蔽场景
🔹 灵活供电——标准 DC12V,支持定制 DC5V
让洁净空气,抵达座艙每一个角落。
| 主动净化座艙,免维护更强大
🔹 双极自清洁等离子技术——释放正负离子,高效去除异味、霉菌、细菌、病毒及污染物
🔹 性能跃升——同体积下,功率更强、离子量更高,较 CM300 净化性能大幅提升
🔹 免维护设计——自研自清洁模块,无需清洁配件,适用于风道、空调内部等隐蔽场景
🔹 灵活供电——标准 DC12V,支持定制 DC5V
让洁净空气,抵达座艙每一个角落。
数量
加入购物车

提供技术支持

沪公网安备31011202022221号
沪公网安备31011202022221号